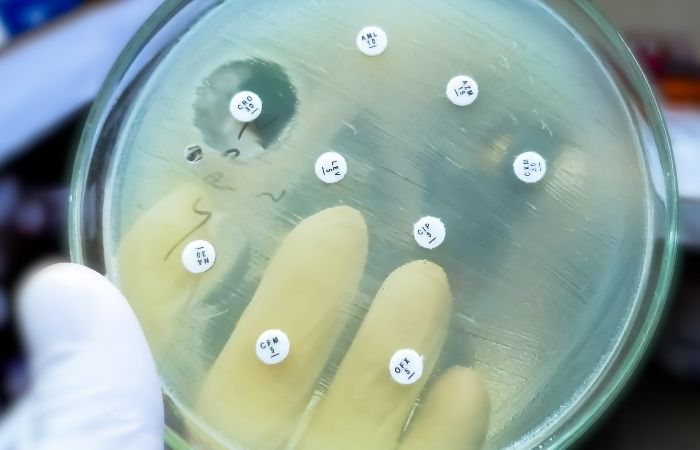
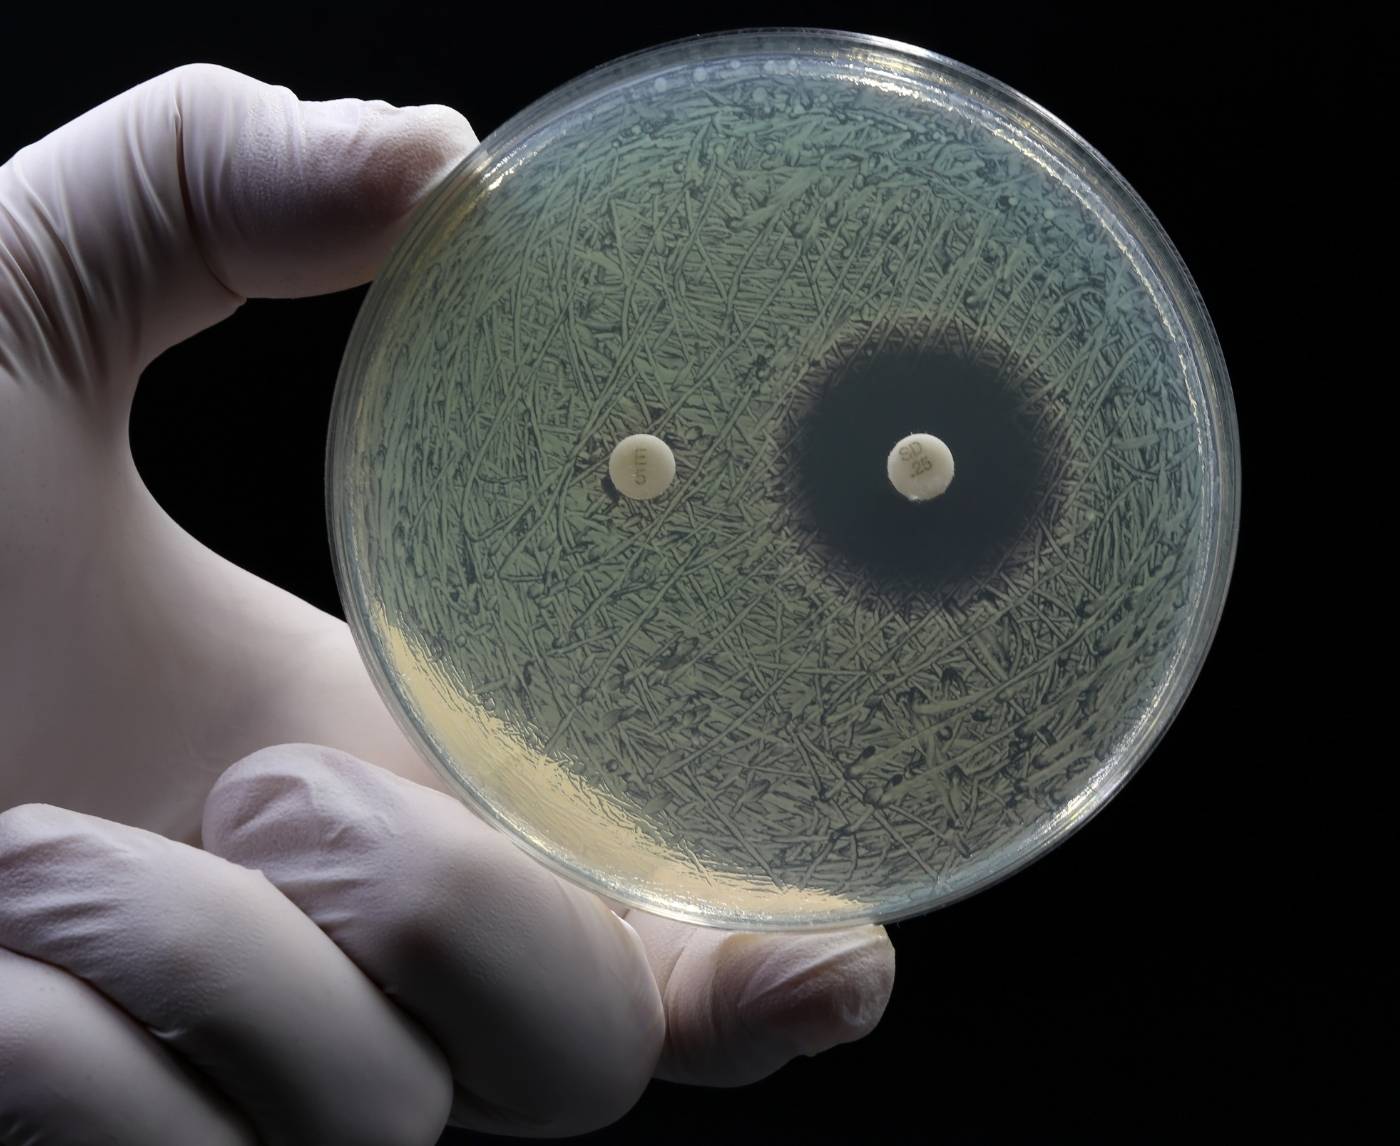
No Symptoms, No Problem? Not With Gonorrhea in 2025

Quick Answer: Gonorrhea is becoming harder to treat due to rising antibiotic resistance. Many people have no symptoms, making it easier to spread. Regular testing and early detection are your best defense.
This Isn’t the Gonorrhea of 10 Years Ago
In the early 2000s, a single shot of ceftriaxone could wipe out gonorrhea in one dose. But bacteria evolve. And like any survivor, Neisseria gonorrhoeae, the bacteria behind the infection, has learned how to fight back. It now resists multiple antibiotics, including the ones we used to trust.
The CDC warned back in 2022 that we were approaching a “post-antibiotic era” of drug-resistant gonorrhea. By 2025, that prediction isn’t theoretical, it’s visible in clinics across the U.S., UK, and Southeast Asia.
- Global Impact: The WHO estimates that more than 82 million people are infected with gonorrhea annually.
- Resistance Hotspots: Southeast Asia, Europe, and parts of the U.S. are reporting strains that resist nearly all available antibiotics.
- CDC Alert: In the U.S., two confirmed cases of extensively drug-resistant gonorrhea were identified in Massachusetts in early 2023.
These aren’t rare headlines. They’re growing trends. And many cases go undetected entirely, because symptoms often never show up.
People are also reading: The STD That Can Grow in Your Nose: When Syphilis Spreads Where You Least Expect
When Silence Is a Symptom Too
Here's the unsettling truth: the most common symptom of gonorrhea in 2025 is nothing at all. Especially for people with infections in the throat, rectum, or cervix.
That’s what makes it so dangerous, no symptoms doesn't mean no infection. You could be carrying and spreading gonorrhea without realizing it, particularly if you’ve had unprotected oral, anal, or vaginal sex.
Here’s how gonorrhea behaves depending on where it shows up:
- Penile infection: Burning during urination, white/yellow/green discharge, testicular pain.
- Vaginal infection: Vaginal discharge, pain during sex, pelvic discomfort, often mistaken for a UTI.
- Rectal infection: Itching, discharge, soreness, bleeding, or no symptoms at all.
- Throat infection: Mild sore throat or none, frequently undiagnosed.
If you’ve ever thought “I feel fine, so I must be fine,” gonorrhea challenges that logic. Especially now.
Case Study: “I Took the Pills. I Thought I Was Cleared.”
Jordan, 27, was diagnosed with gonorrhea after a routine test. “I didn’t have symptoms, but my partner tested positive and told me to get checked. I went to urgent care, took the antibiotics, and thought that was it.”
“A month later, they called me back. My cultures showed the strain didn’t respond to what I was given. I had to go back for a second round, and warn my partners again. That was the worst part.”
Jordan’s story isn’t unique. Many patients never follow up after taking medication, assuming the infection is gone. But with resistant strains, that assumption can be dangerously wrong.
Doctors now recommend test-of-cure follow-ups for suspected resistant cases. But most people don’t know that, and many clinics still don’t offer follow-up cultures unless symptoms persist.
That’s why understanding your options (and asking the right questions) is more important than ever.
Check Your STD Status in Minutes
Test at Home with Remedium7-in-1 STD Test Kit

Order Now $129.00 $343.00
For all 7 tests
Super Gonorrhea: Scary Name, Serious Problem
Let’s get something straight, “super gonorrhea” isn’t science fiction. It’s the nickname for strains of gonorrhea that resist nearly all known antibiotics. It first made headlines in Japan in 2011, and since then, clusters have appeared in the UK, Australia, and the U.S.
These strains aren’t common, but they’re not isolated, either. The term refers to infections that have developed resistance to:
- Cephalosporins (like ceftriaxone)
- Macrolides (like azithromycin)
- Fluoroquinolones (like ciprofloxacin)
That leaves doctors with limited options. In some cases, they’ve had to experiment with dual therapy combinations or repurposed older antibiotics like gentamicin, drugs that may be less effective or have more side effects.
But what’s worse? These strains often present exactly like treatable gonorrhea, or with no symptoms at all. The only way to know if your infection is resistant is through lab culture and susceptibility testing, which many urgent care clinics don’t routinely perform.
When the Antibiotics Don’t Work
Failed treatment doesn’t always look dramatic. Sometimes it’s subtle: the burn comes back. The discharge never fully goes away. Or you test positive again and think, “Maybe I got reinfected.” But what if you didn’t?
According to a 2024 CDC report, treatment failure rates are slowly rising, especially for throat and rectal infections. These locations are harder to clear and easier to miss during testing.
If you’re worried that your gonorrhea treatment didn’t work, here are signs to watch for:
- Persistent symptoms after 7–14 days
- Repeat positive test within 4–6 weeks of treatment
- Partner symptoms returning even if you finished treatment
Here’s what to do:
- Retest: Use an at-home or clinical test to confirm if the infection is still active.
- Request a culture: Ask your provider for resistance testing (especially for throat or rectal infections).
- Notify partners: Don’t assume it was a new exposure, your treatment may have failed.
It’s not your fault. Gonorrhea is changing. And so should how we test for it.

People are also looking for: How Long Do Oral STDs Last in the Throat? What Science and Survivors Say
Why At-Home Testing Matters More Than Ever
When treatment isn’t guaranteed, early detection is everything. And the best way to catch gonorrhea before it spreads, or mutates, is by testing regularly, especially if you're sexually active with multiple partners.
At-home test kits are fast, discreet, and increasingly reliable. For many, they’ve become a trusted alternative to awkward clinic visits or delayed appointments.
- No symptoms? That’s the perfect time to test.
- Between partners? Test and reset your baseline.
- Already treated? Retest after 3–4 weeks to confirm clearance.
You can order a Combo STD Test Kit that checks for gonorrhea, chlamydia, syphilis, and more, right from home, without judgment or delay.
This isn’t just about peace of mind. It’s about protecting yourself and others from a disease that’s no longer predictable.
Case Study: “It Kept Coming Back. I Thought I Was Dirty.”
Lena, 32, was treated for gonorrhea three times in two years. Each time, her doctor blamed “reinfection.” She blamed herself.
“I was careful. I used condoms. But it kept showing up on tests. I thought maybe I was the problem, like I wasn’t worth staying clean.”
Eventually, she was referred to an infectious disease specialist. Turns out, her strain was resistant to the standard treatment, and she’d never been fully cured.
“They gave me a different antibiotic combo. It finally worked. But I wish someone had told me sooner that resistance was even possible. I thought I was dirty. But it wasn’t me. It was the bacteria.”
Gonorrhea thrives on silence, internal and external. The more we talk about resistance, the faster we stop the cycle.
Prevention in 2025: What Still Works, What Doesn’t
Let’s be clear: condoms still work. But they’re not a bulletproof shield, especially when it comes to oral and rectal gonorrhea. The infection transmits through skin-to-skin contact and mucous membranes, so activities like oral sex, rimming, or using shared sex toys can spread it even when condoms are involved.
That doesn’t mean you're doomed. It means prevention has to go beyond protection. Here’s what works now:
- Test between partners: Reset your status before starting something new.
- Use condoms and dental dams: Especially for new or casual partners.
- Don’t skip oral sex risks: Gonorrhea thrives in the throat, and often hides there.
- Clean toys between uses: Use condoms on insertable toys if sharing.
- Retest after treatment: Always. Especially if symptoms linger or return.
Prevention isn’t about blame, it’s about strategy. You’re not reckless for having sex. You’re smart for learning how to make it safer.
Check Your STD Status in Minutes
Test at Home with RemediumGonorrhea Test Kit

Order Now $33.99 $49.00
What Your Doctor Might Miss (But You Shouldn’t)
Here’s a hard pill: even in 2025, many urgent care clinics and general practitioners aren’t equipped to detect antibiotic-resistant gonorrhea. Why? Because they often use nucleic acid amplification tests (NAATs), which confirm presence, but don’t test for resistance.
Culture testing is the gold standard for determining what treatments will work, but it’s expensive, slower, and not always offered.
So what can you do?
- Ask for a culture test: Especially if symptoms persist after treatment.
- Mention resistance: Say you’ve read about resistant strains, this flags your provider to take extra steps.
- Get site-specific tests: If you’ve had oral or anal sex, ask to be tested at those sites, not just genitals.
It’s not “difficult” or “dramatic” to ask for full testing. It’s informed. Doctors might overlook things, they’re human. But your health isn’t optional.
When to Retest, and Why It’s Not Optional Anymore
Too many people treat STD testing like a one-and-done thing. But with gonorrhea evolving fast, testing has to be part of your sexual routine, not just your emergencies.
Here’s when you should definitely test or retest:
- 3–4 weeks after treatment: Especially if you weren’t tested by culture or still feel off.
- Every 3–6 months: If you have new or multiple partners, regardless of symptoms.
- After a partner tests positive: Even if you feel fine and used protection.
- Before a new relationship: Set the tone with transparency and shared safety.
Testing isn’t just reactive anymore. It’s protective. And with discreet options like STD Rapid Test Kits, there’s no excuse to delay.
Case Study: “I Thought I Was Cured. Then I Gave It to Someone Else.”
Marcus, 25, didn’t get retested after taking antibiotics for gonorrhea. He felt better, so he assumed he was fine. But the bacteria wasn’t gone, and he passed it to his next partner without knowing.
“I didn’t mean to. I didn’t know you were supposed to retest. She found out first, then I had to go back and get checked again. I felt like I betrayed her, and myself.”
Marcus didn’t fail. He just didn’t have the full picture. Most people don’t. That’s why sharing this info matters, because no one should be blindsided by an infection that was supposed to be gone.
Why Gonorrhea Keeps Coming Back (Even When You Think It’s Gone)
Reinfection is real, but it’s often misunderstood. Some people go through treatment only to test positive again weeks later. So is it a new infection? Or did the old one never go away?
Here’s the hard part: both are possible. In 2025, you can clear the symptoms and still carry low-level, untreated gonorrhea, especially in the throat or rectum. And if your partner wasn’t treated at the same time, you might just be passing it back and forth.
What contributes to repeat positives:
- Undetected site infections: Not testing the throat or rectum means partial clearance.
- Resistance: Standard meds may not be strong enough anymore.
- Partner ping-pong: One person is treated, the other isn’t, repeat cycle begins.
It's not about being “clean” or “dirty.” It’s about understanding how easily this infection hides, and being proactive, not reactive, with testing and treatment.

People are also reading: From Gums to Tonsils: The STD Symptoms Dentists Are Catching First
What Makes 2025 Different? New Strains, New Challenges
We’re no longer fighting the same infection as we were 10 years ago. Gonorrhea in 2025 isn’t just persistent, it’s mutating. And the rise of global travel, asymptomatic carriers, and declining condom use among certain age groups all add fuel to the fire.
Noteworthy developments this year:
- Hybrid strains: Some infections now carry resistance markers from multiple regions, making treatment harder.
- Younger demographics: Infection rates among people aged 18–29 have climbed sharply since 2022.
- Throat as a reservoir: Studies show the throat is now a key driver of reinfection and resistance, due to frequent missed diagnoses.
Translation? We need more than awareness, we need strategy, testing accessibility, and real conversations about what risk actually looks like.
Take Back Control: What You Can Do Today
This isn’t a fear story, it’s a call to clarity. Gonorrhea may be getting stronger, but your tools are getting smarter. Whether you’re symptom-free or stuck in the “I think it’s back” phase, you deserve answers that don’t involve waiting weeks for an appointment or guessing through Google.
Here’s where to start:
- Order an at-home test: Use a trusted service like STD Rapid Test Kits to test in privacy.
- Ask for full-panel testing: Don't assume it's just one infection, STDs often travel in packs.
- Retest, even without symptoms: Especially if you've been treated in the past 6 weeks.
- Normalize testing with partners: Turn awkward into empowering, it sets the tone for honesty and care.
This isn’t just about gonorrhea. It’s about knowing your body, your status, and your next move. Because silence helps bacteria win, and you’re not here to play their game.
FAQs
1. Is it possible to have gonorrhea and not show any symptoms?
Yes. A lot of people, especially those with throat, rectal, or cervical infections, don't have any symptoms at all. This is why regular testing is so important.
2. What does "super gonorrhea" mean?
Super gonorrhea is a type of gonorrhea that is resistant to almost all antibiotics that are usually used to treat it. It's not common, but it's happening more and more around the world.
3. Why didn't my treatment for gonorrhea work?
If your symptoms don't go away or come back, the antibiotics you were given might not work on the infection, or it might not have been completely cleared from all areas (like the throat or rectum).
4. How can I tell if I got sick again or never got better?
The only way to be sure is to test again 3–4 weeks after treatment. If you didn't test your throat or rectum, the areas that weren't treated could still be infected.
5. Can you get gonorrhea from having oral sex?
Yes. Even if there are no symptoms and no ejaculation, oral sex can spread gonorrhea to and from the throat.
6. Does a test you do at home check for gonorrhea in the throat or rectum?
Some do, but not all. If you've had oral or anal sex, make sure to choose a test that includes site-specific swabs.
7. When should I retest for gonorrhea after treatment?
The CDC says that you should get tested again after 3–4 weeks, especially if the first infection was drug-resistant or outside of the genitals (throat/rectum).
8. Can I still give someone gonorrhea after I've been treated?
Yes, if your treatment didn't work all the way or if your partner didn't get treated either. Reinfection between partners happens a lot.
9. Is there a way to get rid of super gonorrhea?
There is no sure way to cure it with just one dose. Treatment may need special combinations of antibiotics and follow-up tests to make sure the infection is gone.
10. Where can I get a quick and private test?
You can order FDA-approved testing kits from STD Rapid Test Kits that are discreet and test at home when it's convenient for you.
You Deserve Answers, Not Assumptions
This isn’t the time to second-guess your symptoms, your status, or your safety. Gonorrhea in 2025 is changing fast, but the way forward is still clear: test early, treat smart, and never assume silence means safety.
Whether you're symptom-free, stuck in a cycle of reinfection, or just unsure what’s going on, you have options, and you don’t have to wait.
Don’t wait and wonder, get the clarity you deserve.
Sources
2. Drug-Resistant Gonorrhea – CDC (current resistance, last-line treatments, urgency of monitoring)
5. Antibiotic Resistance in Gonorrhea – Wikipedia (mechanisms of resistance, evolution over time)